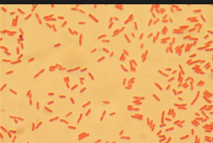

Sign up for FlowVella
Sign up with FacebookAlready have an account? Sign in now
By registering you are agreeing to our
Terms of Service
Loading Flow
Animal name:Duckbill platypus
Plant name : northern arrow wood
Taxonomy :
Kingdom : plantae
Phylum : tracheorbionta
Class: magnoliopsida
Order: dipscales
Family : caprifoliaceae
Genus: viburnum
Species : recogitum
Multicellular, cell wall, prokaryotic, autotrophic,
Relatives :
Multicellular, has nucleus, eukaryotic and heterotrophic
Relatives : echidna
Phylum characteristics : has hollow nerve chord, has notochord, digestive tube behind mouth.
Taxonomy:
Kingdom: Anamalia
Phylum: Chordata
Class : Mammalia
Order : monotremata
Family : Ornithorhynchidae
Genus : Ornithorhynchus
Species : anatinyus
Eubacteria name : e. Coli Multicellular
Kingdom : bacteria Prokaryotic
Phylum : proteobacteria Autotrophic
Class : gamma pro bacteria Gram negative strian
Order : enterobacteriales. Shape : cylinder
Family : enterobacteriaceae
Genus : escherichia
Species : escherichia coli